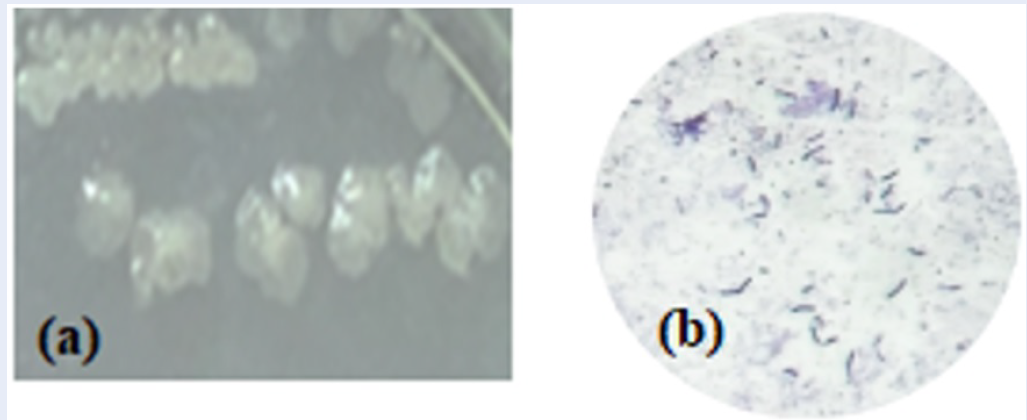

Thi Yen Nhi Nguyen, Thuan Khiet Trinh Nguyen, Nguyen Minh Tam Phan, Thi My Duyen Truong, Thao Vy Duong, Thi Duyen Diep, Thanh Thien Co

Duc Hieu Nguyen, Quoc Anh Hoang, Binh Minh Tu, Manh Tri Tran, Minh Huong Giang Dang, Bich Ngoc Hoang, Van Tu Vu, Thi Hong Yen Nguyen, Takahashi Shin

Thi Yen Hang BUI, The Nga Tran
Nhung Thi Dang, Thao Thi-Hong Phan, Huong Thi Tran, Tra Thi Le, Lien Thi-Hong Nguyen, Tam Kieu-Bang Nguyen, Huu Van Ngo, Son Van Cao

My-Phuc Vo-Ho, Thuy-Vy Nguyen, Dao Thi-Hong Pham

Vuong Thanh Tuyen, Nguyen Ba Tong, Hieu Van Le, Cao Thi My Dung, Tran Thi Thanh Van

Ha Phuong Phan La, Phat Hong Nghia Tran, Thach Bui Khac, Giang Thuy Thanh Le, Hao Duc Nguyen, Viet Van Pham

Le Ngoc Thu Nguyen, Hoai Nhan Luong, Ngoc Bao Tri Pham, Le Thai Duy, Cong Khanh Tran, Ngoc Phuong Nguyen, Vinh Quang Dang

Olubukola Olayemi Olusola-Makinde, Olayiwola Sola Ajayi, Clement Olusola Ogidi

Thai Thi Thuy Oanh, Alang Tho